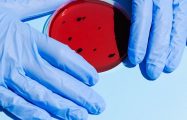

There are many things that set us apart.
But the basics of what makes us and our work unique are simple.
- You
- come first. Rather than a ‘cut and paste’ house style, we create eclectic, timeless and thoughtful designs that capture you and your story with beauty and a sense of playfulness.
- Practicality
- lies at the heart of what we do. See your home brought to life with useful and creative considerations, designed to make your life easier and happier.
- Longevity
- and style are fundamental to our work. Free from fads and fashions, each carefully curated interior is built with care and craftsmanship at its core.
- Acclaimed
- in the design world. We are a notable and award-winning studio having been recognised on House & Garden’s Top 100 Interior Designers and Architects list since 2021.

Ours is a purposefully small team, working closely with associate architects and trusted craftspeople. Our size and close connections allow us to offer a highly personal service – one rooted in creativity, functionality and genuine collaboration. We’re proud to have been recognised as an award-winning interior design studio, featured on the House & Garden Top 100 Interior Designers list since 2021. But as much as we value that recognition, it’s the relationships we build – and the clients who return to us project after project – that bring us the greatest satisfaction.